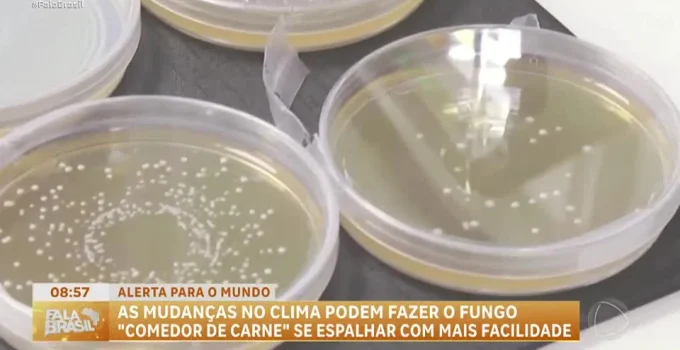
Fungo de transmissão sexual, 'percevejo sexual', gera alerta global e preocupa por resistência a antifúngicos

Um fungo altamente contagioso, conhecido como Trichophyton mentagrophytes tipo VII (TMVII) e apelidado de “percevejo sexual”, está acendendo um alerta de saúde pública em diversas partes do mundo. Casos foram confirmados em países da Europa, nos Estados Unidos e no Canadá, além de regiões no Oriente Médio. A doença, uma micose que causa erupções cutâneas, pode se manifestar até três semanas após o contágio e é transmitida principalmente por contato direto, incluindo relações sexuais.
O que é o TMVII e como ele se espalha?
O TMVII é um tipo de dermatófito, um fungo microscópico que se alimenta de queratina, encontrada na pele, cabelos e unhas. A infecção, conhecida popularmente como “coceira na virilha” quando afeta a região genital, tem se mostrado resistente aos tratamentos antifúngicos convencionais, o que aumenta a preocupação das autoridades de saúde. Embora não seja fatal, a micose pode deixar cicatrizes e danos permanentes na pele se não for tratada adequadamente.
CONTINUA APÓS O ANÚNCIO
A disseminação global do fungo ganhou força após casos identificados na França em 2021, que se espalharam para outros países europeus como Alemanha e Espanha. Nos Estados Unidos, o primeiro caso documentado em julho de 2025 no Minnesota já soma 13 infecções. A hipótese de que a infecção estivesse ligada a viagens ao Sudeste Asiático perdeu força com um caso americano que se desenvolveu após retorno da Europa, indicando rotas de contágio mais amplas.
Sintomas e diagnóstico desafiador
Os sintomas do TMVII podem levar até três semanas para aparecer após a infecção. As erupções cutâneas, que podem surgir em diversas partes do corpo como rosto, membros, virilha e pés, geralmente começam como pequenas manchas vermelhas e pruriginosas. Com o tempo, as lesões podem se expandir, tornando-se escamosas, inflamadas e dolorosas.
O diagnóstico da infecção é realizado por meio de coleta de amostras da pele afetada, que são enviadas para análise laboratorial. A dificuldade no diagnóstico precoce e a resistência aos antifúngicos são fatores que agravam a situação.
CONTINUA APÓS O ANÚNCIO
Resistência antifúngica: uma ameaça global
O surto do TMVII ocorre em um contexto de crescente preocupação com a resistência de fungos patogênicos a medicamentos. A Organização Mundial da Saúde (OMS) já alertou em 2022 que o aumento da resistência antifúngica representa uma “implicação importante” para a saúde global. Fungos comuns como a Candida, causadora da candidíase, estão se tornando cada vez mais difíceis de tratar, exigindo novas abordagens terapêuticas e maior vigilância.
Especialistas como Neil Stone, consultor em doenças infecciosas do University College London Hospitals, alertam que a doença “inevitavelmente, vai se espalhar pelo mundo todo”. Ele enfatiza a necessidade de os médicos estarem preparados para reconhecer os sintomas, realizar os testes corretos e buscar aconselhamento especializado para o tratamento eficaz do TMVII. A transmissão, embora associada a contato íntimo, também pode ocorrer por meio de objetos compartilhados como toalhas e roupas de cama.
A rápida disseminação do fungo e sua resistência a tratamentos convencionais exigem atenção internacional e o reforço de medidas de prevenção e controle para evitar que se torne uma crise de saúde pública de maiores proporções.
CONTINUA APÓS O ANÚNCIO
Fonte: R7